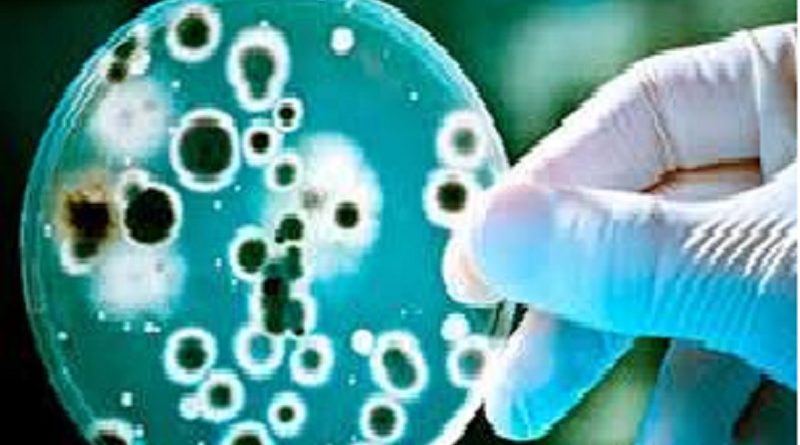
virus

Fungo mortal para plantas é detectado pela primeira vez em um ser humano
É extremamente raro que patógenos desse tipo consigam se desenvolver no corpo humano (Foto:Reprodução).
O Chondrostereum purpureum estava enraizado na garganta de um homem de 61 anos
Uma infecção causada pelo fungo vegetal Chondrostereum purpureum foi registrada, pela primeira vez na história, em um ser humano. O patógeno é responsável por desencadear doenças nas plantas, chegando a matá-las se não forem tratada rapidamente.
O estudo foi publicado no dia 15 de março pelo periódico Medical Mycology Case Reports, e descreve o caso de um micologista indiano de 61 anos que contraiu o fungo e desenvolveu um quadro grave de doença da folha de prata na garganta, considerada rara.
“Este caso destaca o potencial de fungos de plantas para causar doenças em humanos e enfatiza a importância de técnicas moleculares para identificar espécies fúngicas”, aponta o estudo feito na Índia.
Os principais sintomas apresentados pelo paciente foram tosse, voz rouca, fadiga e dificuldade para engolir. Os médicos fizeram uma tomografia computadorizada no indiano e encontraram uma bolsa cheia de pus ao lado da traqueia. Entretanto, os exames laboratoriais não detectaram a presença de nenhuma bactéria preocupante.
Detecção do fungo
Os médicos decidiram usar uma técnica de coloração para fungos que revelou a existência de hifas — longos filamentos semelhantes a raízes.
Após perceberem que a infecção do indiano não se parecia com nenhuma das comuns, os especialistas procuraram um centro de referência e pesquisa de fungos da Organização Mundial da Saúde (OMS), que constatou o DNA do patógeno.
O paciente não recordava ter trabalhado com a espécie recentemente. No entanto, o trabalho de campo o colocou em contato com material em decomposição e outros fungos vegetais.
É extremamente raro que patógenos desse tipo consigam enfiar as hifas através de folhas e caules dentro do corpo humano, pois precisam de um meio que garanta os nutrientes certos e formas de se defender.
O estudo relata que o sistema imunológico do paciente estava em pleno funcionamento, sem nenhuma indicação de drogas imunossupressoras, HIV, diabetes ou qualquer tipo de doença crônica, o que torna o caso ainda mais surpreendente.
Por:Jornal Folha do Progresso/ Com informações de Emilly Melo, em 04/04/2023/17:39:01
O formato de distribuição de notícias do Jornal Folha do Progresso pelo celular mudou. A partir de agora, as notícias chegarão diretamente pelo formato Comunidades, uma das inovações lançadas pelo WhatsApp. Não é preciso ser assinante para receber o serviço. Assim, o internauta pode ter, na palma da mão, matérias verificadas e com credibilidade. Para passar a receber as notícias do Jornal Folha do Progresso, clique no link abaixo e entre na comunidade:
* Clique aqui e acesse a comunidade do JORNAL FOLHA DO PROGRESSO
Apenas os administradores do grupo poderão mandar mensagens e saber quem são os integrantes da comunidade. Dessa forma, evitamos qualquer tipo de interação indevida. Sugestão de pauta enviar no e-mail:folhadoprogresso.jornal@gmail.com.
Envie vídeos, fotos e sugestões de pauta para a redação do JFP (JORNAL FOLHA DO PROGRESSO) Telefones: WhatsApp (93) 98404 6835– (93) 98117 7649.
“Informação publicada é informação pública. Porém, para chegar até você, um grupo de pessoas trabalhou para isso. Seja ético. Copiou? Informe a fonte.”
Publicado por Jornal Folha do Progresso, Fone para contato 93 981177649 (Tim) WhatsApp:-93- 984046835 (Claro) -Site: www.folhadoprogresso.com.br e-mail:folhadoprogresso.jornal@gmail.com/ou e-mail: adeciopiran.blog@gmail.com